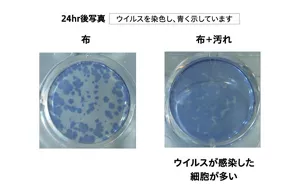
布の感染性評価の結果を示す写真。 細胞の中のウイルスを青く染色。汚れが付いた布で行った結果の方が、汚れがない布で行った結果よりも、ウイルスが感染した細胞を示す青色の面積が広い。

最近の研究で、ウイルスがプラスチック、紙、衣類などに付着したとき、素材によって“ウイルスが感染力を保つ時間”が異なることが明らかになりました※1 。では衣類において、汚れがある時とない時で、その時間は変わるのでしょうか。衣類の上で、汚れとウイルスが共存しているときの検証結果をご紹介します。
汚れのない布と汚れがある布を使って、ウイルスがその力をどれだけ維持するかを測定※2 した結果、汚れがある布のほうが、ウイルスが感染力を長時間保つことがわかりました。
感染性評価結果
日常生活において、衣類にウイルスと汚れを共存させないことが重要と考えられます。衣類にウイルスが付着していた場合、汚れと一緒の状態で放置すると、ウイルスの力が失われにくくなる可能性があります。汚れた衣類はため込まずに、こまめにお洗濯することがおすすめです。
